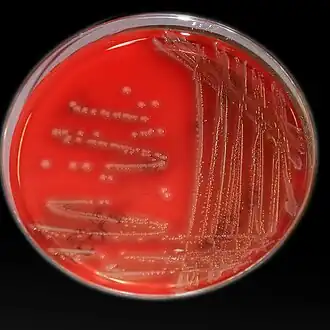

Photobakterien
| Photobakterien | ||||||||||||
|---|---|---|---|---|---|---|---|---|---|---|---|---|
Photobacterium damselae | ||||||||||||
| Systematik | ||||||||||||
| ||||||||||||
| Wissenschaftlicher Name | ||||||||||||
| Photobacterium | ||||||||||||
| Beijerinck 1889 |
Photobakterien (Photobacterium) sind eine Gattung von gramnegativen Bakterien und gehören zur Familie der Vibrionaceae. Einige Mitglieder dieser Gattung haben die Fähigkeit Licht zu erzeugen und sind somit biolumineszent. Darauf deutet der Gattungsname hin, die Silbe Photo kommt von dem altgriechischen Wort φῶς phos (das Licht).
Viele Arten, eingeschlossen Photobacterium leiognathi und Photobacterium phosphoreum, leben in Symbiose mit Meereslebewesen. Arten wie Photobacterium profundum sind an ein optimales Wachstum in tiefen kalten Meeren oder Seen angepasst. Sie sind psychrophil (kälteliebend) und barophil (druckliebend).
Merkmale
Die Bakterien treten als gerade oder gekrümmte Stäbchen mit den Abmessungen 0,8–1,3 × 1,8–2,4 µm[1] auf. Die Gram-Färbung fällt negativ aus, es sind somit gramnegative Bakterien. Mit Ausnahme von P. damselae subsp. piscicida[1] bewegen sie sich mittels meist 1 bis 3 nicht membranumhüllter,[1] polarer Flagellen. Endosporen werden nicht gebildet. Die Bakterien sind chemotroph und zur Fermentation (Gärung) fähig. Zum Wachstum benötigen sie Natrium.
Ökologie
Photobakterien sind vorwiegend Meereslebewesen (daher die Verwendung von Natrium zum Wachstum). Sie können freilebend sein oder in Kolonien auftreten. Diese Organismen enthalten keine Pigmentierung und ihre Kolonien erscheinen daher weiß oder farblos. Wenn es eine hohe Dichte an Zellen gibt, die eine Kolonie bilden, zeigen sie Biolumineszenz. Diese basiert auf Autoinduktoren, welche proportional zur Zelldichte sind. Deshalb leuchten freilebende Photobakterien nicht.[2]
Ihre Besiedelung von Fischen könnte symbiotischer Natur sein, nämlich zur Bildung von Leuchtorganen als eine neutrale Einheit an der Oberfläche oder innerhalb des Darms der Fische. Auch als Schutz vor Krankheiten wird ihr Vorkommen in Fischen diskutiert.
Pathogenität
Einige der 23 bekannten Arten von Photobacterium haben sich zu Krankheitserregern von Meereslebewesen entwickelt. Viele dieser Krankheiten beeinflussen handelswichtige Fische und können indirekt, durch deren Konsum, die menschliche Gesundheit beeinflussen. Unter anderem wurde beobachtet, wie das Chitin der Tiefseekrabbe (Chinoecetes tanneri) abgebaut wurde.
Zu der Art Photobacterium damselae gehören die virulentesten Stämme. Diese Art wird in zwei Unterarten aufgeteilt: P. d. subsp. piscicida und P. d. subsp. damsela.[3]
Photobacterium damselae subsp. piscicida
Photobacterium damselae subsp. piscicida ist der Erreger der Fisch-Pasteurellose. Bakterienkolonien wachsen an der infizierten Milz und Niere des Fisches und führen schließlich zum Tod. Diese Krankheit ist verantwortlich für große Verluste in einigen Fischzuchtunternehmen. Zu den betroffenen Arten zählen unter anderem der Gelbflossen-Thunfisch (Thunnus albacares), gewisse Meerbrassen (Sparus spp.), der Streifenbarsch (Marone saxatilis) und Wolfsbarsche (Marone americana). Photobacterium damselae subsp. piscicida ist nicht pathogen für Menschen.[4]
Photobacterium damselae subsp. damselae
Die Unterart P. d. subsp. damselae befällt ebenfalls Fische. Es verursacht in einigen Fischspezies eine Sepsis wie beispielsweise bei Riffbarschen (Familie Pomacentridae), Aalen (Anguilla anguilla), Sandbankhaien (Carcharhinus plumbeus), Stachelmakrelen (Seriiola quinqueradiata), Meerbrassen (Sparus spp.) und dem Steinbutt (Scophthalmus spp.). Diese Unterart hat sich als pathogen für den Menschen erwiesen, als es sich von menschlichen Wunden ausbreitete und eine Sepsis bei gesunden Menschen verursachte.[5]
Symptome
Fische, die mit der Unterart P. d. subsp. damselae infiziert wurden, wiesen zunächst Symptome wie einen reduzierten Appetit auf, begleitet von Energielosigkeit und eiternden Wunden entlang ihrer Flanken und in der Kopfregion. Ihre Mägen blähten sich auf und sie bekamen erhebliche Blutungen, speziell in Augen, Mund und Muskulatur. Zusätzlich traten Blutungen in Leber und Kiemen mit charakteristischer Ansammlung von Schleim um diese auf. Es wurde festgestellt, dass die infizierten Fische, einige Minuten bevor der Tod eintrat, schneller schwammen.
Transmission/Infektion
Anzeichen für die Verbreitung dieser Tierseuche sind Anhäufungen von Geschwüren bei der Fischpopulation, meist in Kombination mit höheren Temperaturen der Umgebung. Die Verbreitung der Krankheit ist saisonal aufgeteilt. Dies erkennt man an der Abhängigkeit von der Wassertemperatur und vom Salzgehalt. Durch physiologische Veränderungen während der sexuellen Reife des Wirtes steigt die Resistenz der Bakterien an.
Hatten sie einmal Kontakt mit der äußeren Oberfläche der Fische, sind sie fähig, sich an die Haut anzuheften und die bakterizide Wirkung der Schleimschicht der Fische zu unterdrücken. Daher wird angenommen, dass die Haut die Zugangsstelle zum Wirt ist. Dieses Bakterium kann zu einer großen Bedrohung für Aquakulturen werden, besonders in überfüllten und beengten Lebensräumen, wodurch die Fische Stress ausgesetzt sind. Die Vermehrung der Krankheit kann durch direkten Kontakt beschleunigt werden.
Nutzen der Biolumineszenz für das Photobacterium leiognathi
Bei Untersuchungen über die Wirkung der lumineszenten Bakterien Photobacterium leiognathi im Meer fand man heraus, dass das Leuchten von Photobakterien für Räuber von großer Bedeutung ist. So werden Nahrungspartikel die vom Photobacterium leiognathi besiedelt sind, schneller entdeckt als die nicht besiedelten. Das Photobacterium leiognathi überlebt in den Eingeweiden des Tieres, vermehrt sich dort und verbreitet sich mit dessen Kot im Wasser. Das hat den Vorteil, dass Photobacterium leiognathi in den Eingeweiden ein sicheres Habitat besiedelt und ihm eine schnelle Verbreitung ermöglicht wird.
Aber nicht nur das Photobacterium leiognathi zieht daraus einen Vorteil, auch der Räuber wird dadurch begünstigt. Er findet in den Tiefen des Meeres, wo Nahrung knapp ist, das leuchtende Futter besser. Jedoch führt die Aufnahme der Nahrung und die damit verbundene Lumineszenz dazu, dass er selbst eine leichtere Beute darstellt, wobei der Vorteil, überhaupt Nahrung zu finden, diesen Nachteil anscheinend überwiegt.
Einige Räuber haben Pigmente in ihren Eingeweiden, die die Lichtemission blockieren und damit dem Nachteil der Lumineszenz entgegenwirken. Das Photobacterium leiognathi wird dadurch erst im Kot wieder sichtbar.[6]
Arten
Einige Arten:[7]
- Photobacterium angustum Reichelt et al. 1979
- Photobacterium aphoticum Lucena et al. 2011
- Photobacterium aplysiae Seo et al. 2005
- Photobacterium aquimaris Yoshizawa et al. 2009
- Photobacterium damselae Smith et al. 1991
- Photobacterium damselae subsp. damselae Gauthier et al. 1995
- Photobacterium damselae subsp. piscicida Gauthier et al. 1995
- Photobacterium frigidiphilum Seo et al. 2005
- Photobacterium gaetbulicola Kim et al. 2010
- Photobacterium ganghwense Park et al. 2006
- Photobacterium halotolerans Rivas et al. 2006
- Photobacterium iliopiscarium Urakawa et al. 1999
- Photobacterium indicum Ivanova et al. 2004
- Photobacterium jeanii Chimetto et al. 2010
- Photobacterium kishitanii Ast et al. 2007
- Photobacterium leiognathi Boisvert et al. 1967
- Photobacterium lipolyticum Yoon et al. 2005
- Photobacterium panuliri Deep 2015[8]
- Photobacterium lutimaris Jung et al. 2007
- Photobacterium phosphoreum Beijerinck 1889
- Photobacterium profundum Nogi et al. 1998
- Photobacterium rosenbergii Nogi et al. 1998
- Photobacterium swingsii Gomez-Gil et al. 2011
Einzelnachweise
- ↑ a b c Dongyou Liu: Molecular Detection of Human Bacterial Pathogens. Crc Press 2011, ISBN 978-1-4398-1238-9, S. 960.
- ↑ K. H. Nealson, J. W. Hastings: Bacterial bioluminescence: its control and ecolocigal significance. In: Microbiological Reviews, Vol. 43, 1979, S. 496–518. PMC 281490 (freier Volltext).
- ↑ Brian Austin, Dawn A. Austin: Bacterial Fish Pathogens: Disease of Farmed and Wild Fish. 4. Ausgabe. Springer Verlag, ISBN 978-1-4020-6068-7.
- ↑ C. R. Osorio, A. E. Toranzo, J. L. Romalde, J. L. Barja: Multiplex PCR assay for ureC and 16S rRNA genes clearly discriminates between both subspecies of Photobacterium damselae. In: Diseases of Aquatic Organisms. Band 40, 2000, doi:10.3354/dao040177, S. 177–183.
- ↑ B. Fouz, A. E. Toranzo, M. Milán, C. Amaro: Evidence that water transmits the disease caused by the fish pathogen Photobacterium damselae subsp. damselae. In: Journal of Applied Microbiology. Volume 88, Issue 3, 25. Dezember 2001, doi:10.1046/j.1365-2672.2000.00992.x.
- ↑ M. Zarubin et al.: Bacterial bioluminescence as a lure for marine zooplankton and fish. In: Proceedings of the National Academy of Sciences. 109, 2012, S. 853, doi:10.1073/pnas.1116683109.
- ↑ LPSN ( des vom 3. März 2012 im Internet Archive) Info: Der Archivlink wurde automatisch eingesetzt und noch nicht geprüft. Bitte prüfe Original- und Archivlink gemäß Anleitung und entferne dann diesen Hinweis., Liste der bekannten Photobakterien, 4. Oktober 2012.
- ↑ Kamal Deep, Abhijit Poddar und Subrata K. Das: Photobacterium panuliri sp. nov., an Alkalitolerant Marine Bacterium Isolated from Eggs of Spiny Lobster, Panulirus penicillatus from Andaman Sea In: Current Microbiology (2014) Band 69, S. 660–668, doi:10.1007/s00284-014-0638-0
Literatur
- Martin Dworkin, Stanley Falkow, Eugene Rosenberg, Karl-Heinz Schleifer, Erko Stackebrandt (Hrsg.) The Prokaryotes, A Handbook of the Biology of Bacteria. 7 Bände, 3. Auflage, Springer-Verlag, New York u. a. O., 2006, Vol. 6: Proteobacteria: Gamma Subclass. ISBN 0-387-30746-X.